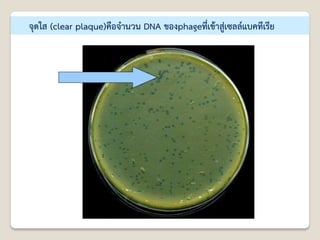
จุดใส (clear plaque)คือจานวน DNA ของphageที่เข้าสู่เซลล์แบคทีเรีย

Recommended
PDF
เอกสารประกอบการสอน เรื่อง พันธุวิศวกรรมและเทคโนโลยีดีเอ็นเอ
PDF
PDF
พันธุศาสตร์และเทคโนโลยีทางDna
PDF
PDF
บทที่ 15 การถ่ายทอดทางพันธุกรรม (2)
PDF
PDF
เรื่องพันธุศาสตร์ genetics ตอนที่ 1
PDF
PDF
บทที่ 6 เทคโนโลยีดีเอ็นเอ
PDF
บทที่ 4 โครโมโซมและสารพันธุกรรม
PDF
PDF
PDF
การศึกษาโครงสร้างของหัวใจหมู โครงสร้างอวัยวะแลกเปลี่ยนแก๊ส และการวัดปริมาตรปอด
PDF
ข้อสอบปลายภาค ภาคเรียนที่ 1 ปีการศึกษา 2555 ชั้น ม.6
PDF
แบบทดสอบ เรื่อง การถ่ายทอดลักษณะทางพันธุกรรม
PDF
PDF
PDF
PDF
PDF
เฉลยแบบฝึกหัด17.5โครงสร้างdna
PDF
บทที่ 15 การถ่ายทอดทางพันธุกรรม
PDF
PPTX
บทที่ 1 ชีวิตกับสิ่งแวดล้อม
PDF
PDF
PDF
การประยุกต์ใช้เทคโนโลยีDna
PDF
PDF
PDF
เอกสาร เรื่อง ยีนและโครโมโซม
PDF
หน่วยการเรียนรู้ที่ 2 เรื่อง ยีนและโครโมโซม
More Related Content
PDF
เอกสารประกอบการสอน เรื่อง พันธุวิศวกรรมและเทคโนโลยีดีเอ็นเอ
PDF
PDF
พันธุศาสตร์และเทคโนโลยีทางDna
PDF
PDF
บทที่ 15 การถ่ายทอดทางพันธุกรรม (2)
PDF
PDF
เรื่องพันธุศาสตร์ genetics ตอนที่ 1
PDF
What's hot
PDF
บทที่ 6 เทคโนโลยีดีเอ็นเอ
PDF
บทที่ 4 โครโมโซมและสารพันธุกรรม
PDF
PDF
PDF
การศึกษาโครงสร้างของหัวใจหมู โครงสร้างอวัยวะแลกเปลี่ยนแก๊ส และการวัดปริมาตรปอด
PDF
ข้อสอบปลายภาค ภาคเรียนที่ 1 ปีการศึกษา 2555 ชั้น ม.6
PDF
แบบทดสอบ เรื่อง การถ่ายทอดลักษณะทางพันธุกรรม
PDF
PDF
PDF
PDF
PDF
เฉลยแบบฝึกหัด17.5โครงสร้างdna
PDF
บทที่ 15 การถ่ายทอดทางพันธุกรรม
PDF
PPTX
บทที่ 1 ชีวิตกับสิ่งแวดล้อม
PDF
PDF
PDF
การประยุกต์ใช้เทคโนโลยีDna
PDF
PDF
Similar to บท3 พันธุเทคโน
PDF
เอกสาร เรื่อง ยีนและโครโมโซม
PDF
หน่วยการเรียนรู้ที่ 2 เรื่อง ยีนและโครโมโซม
PDF
PDF
PDF
Key9 saman genetics_kruwichaitu
PDF
บทที่ 18 พันธุศาสตร์และเทคโนโลยีชีวภาพ
PDF
เทคโนโลยีชีวภาพกับการขยายพันธุ์สัตว์
PDF
PDF
PPT
พันธุศาสตร์และเทคโนโลยีทาง Dna
PDF
ยีนและโครโมโซม ม.6/2 กลุ่มที่2 โรงเรียนมัธยมวัดใหม่กรงทองในพระราชูปถัมภ์ฯ
PDF
PDF
PDF
PDF
PPT
PDF
PDF
PDF
PDF
More from Wichai Likitponrak
PDF
บท4ระบบสุริยะ_ครูวิชัย ลิขิตพรรักษ์ วิชาวิทยาศาสตร์ ม.3 เทอม1 / 2567.pdf
PDF
บทที่4วัสดุในชีวิตประจำวัน_ครูวิชัย ลิขิตพรรักษ์ วิชาวิทยาศาสตร์ ม.3 เทอม2 / ...
PDF
บท3ไฟฟ้า_ครูวิชัย ลิขิตพรรักษ์ วิชาวิทยาศาสตร์ ม.3 เทอม1 / 2567.pdf
PDF
บทที่3ปฏิกิริยาเคมี_ครูวิชัย ลิขิตพรรักษ์ วิชาวิทยาศาสตร์ ม.3 เทอม2 / 2567.pdf
PDF
บท2ระบบนิเวศ_ครูวิชัย ลิขิตพรรักษ์ วิชาวิทยาศาสตร์ ม.3 เทอม1 / 2567.pdf
PDF
บทที่ 5 พฤติกรรมสัตว์ รายวิชาชีววิทยา 4 ภาคเรียน 1 /2567_ครูวิชัย.pdf
PDF
บทที่ 3 ทรัพยากรสิ่งแวดล้อม วิชาชีววิทยา 5 ภาคเรียน 2/2567_ครูวิชัย.pdf
PDF
บทที่ 3 สืบพันธุ์เจริญเติบโตสัตว์ รายวิชาชีววิทยา 4 ภาคเรียน 1 /2567_ครูวิชัย...
PDF
บทที่ 1 หลายหลากชีวภาพ วิชาชีววิทยา 5 ภาคเรียน 2/2567_ครูวิชัย.pdf
PDF
บท1พันธุกรรม_ครูวิชัย ลิขิตพรรักษ์ วิชาวิทยาศาสตร์ ม.3 เทอม1 / 2567.pdf
PDF
แผนการจัดการเรียนรู้ชีววิทยาพื้นฐาน-ครูวิชัย.pdf
PDF
บทที่ 2 ระบบนิเวศ วิชาชีววิทยา 5 ภาคเรียน 2/2567_ครูวิชัย.pdf
PDF
บทที่2แสง_ครูวิชัย ลิขิตพรรักษ์ วิชาวิทยาศาสตร์ ม.3 เทอม2 / 2567.pdf
PDF
บทที่ 1 ระบบประสาท รายวิชาชีววิทยา 4 ภาคเรียน 1 /2567_ครูวิชัย.pdf
PDF
ใบงานประกอบแผนการจัดการเรียนรู้ชีววิทยาพื้นฐาน-ครูวิชัย.pdf
PDF
บทที่1คลื่น_ครูวิชัย ลิขิตพรรักษ์ วิชาวิทยาศาสตร์ ม.3 เทอม2 / 2567.pdf
PDF
บันทึกข้อความประเมินดับเพลิง2565_ครูวิชัย
PDF
บันทึกข้อความประเมินรับสมัครGS2565_ครูวิชัย
PDF
บทที่ 4 โครงสร้างเคลื่อนที่สัตว์ รายวิชาชีววิทยา 4 ภาคเรียน 1 /2567_ครูวิชัย.pdf
PDF
บทที่ 2 ต่อมไร้ท่อ รายวิชาชีววิทยา 4 ภาคเรียน 1 /2567_ครูวิชัย.pdf
บท3 พันธุเทคโน 1. บทที่ 3 พันธุศาสตร์และเทคโนโลยี DNA
(Genetic and DNA technology)
รายวิชาชีววิทยา 4 (ว30246)
ภาคเรียนที่ 2 ปีการศึกษา 2558
นายวิชัย ลิขิตพรรักษ์
ครู คศ.1 สาขาวิชาชีววิทยา กลุ่มสาระการเรียนรู้วิทยาศาสตร์
2. ครูผู้สอน
นายวิชัย ลิขิตพรรักษ์ ตาแหน่งครู คศ.1 เอกวิชาชีววิทยา
ประวัติการศึกษา :
◦ พ.ศ. 2549 วิทยาศาสตรบัณฑิต (เกีรยตินิยมอันดับ 2) สาขาชีววิทยา คณะวิทยาศาสตร์
มหาวิทยาลัยมหิดล
◦ พ.ศ. 2551 ศึกษาศาสตรบัณฑิต สาขาวิชาศึกษาศาสตร์ เอกเทคโนโลยีและสื่อสารการศึกษา
มหาวิทยาลัยสุโขทัยธรรมาธิราช
◦ พ.ศ. 2552 ประกาศนียบัตรบัณฑิตวิชาชีพครู คณะครุศาสตร์ มหาวิทยาลัยราชภัฏสวนดุสิต
◦ พ.ศ. 2555 สาธารณสุขศาสตรบัณฑิต สาขาวิชาวิทยาศาสตร์สุขภาพ เอกสาธารณสุขศาสตร์
มหาวิทยาลัยสุโขทัยธรรมาธิราช
◦ พ.ศ. 2558 ศึกษาศาสตรมหาบัณฑิต สาขาวิชาการประเมินและการวิจัยทางการศึกษา
เอกวิจัยทางการศึกษา คณะศึกษาศาสตร์ มหาวิทยาลัยรามคาแหง
3. 4. 5. 6. การคัดเลือกพันธุ์และการปรับปรุงพันธุ์โดยคน การคัดเลือกโดยคนจะเกิดสิ่งมีชีวิตที่มีลักษณะดีเด่นตาม
ความต้องการของคน เช่น การคัดเลือกพันธุ์ปลาทับทิม (การเจริญเติบโตเร็วมีส่วนที่เป็นเนื้อมาก โครงกระดูก
เล็ก ก้างน้อย เส้นใยกล้ามเนื้อละเอียด รสชาติดี ไม่มีกลิ่นที่เกิดจากไขมันปลา ต้านทานต่อโรค : พัฒนามาจาก
พันธุ์ปลานิลทั่วโลกผสมข้ามพันธุ์) การปรับปรุงพันธุ์ข้าว (พันธุ์ข้าวพันธุ์ดีที่นามาใช้ คือ พันธุ์ข้าวขาวดอกมะลิ
105 ปลูกได้ทุกภาค ใช้เวลา 160 วัน ทนแล้งและดินเปรี้ยวดินเค็ม มาอาบรังสีแกมมา เกิดมิวเทชันได้พันธุ์ข้าว
กข 6 กข 10 และกข 15 ที่มีลักษณะดีขึ้นคือ กข 6 เป็นพันธุ์ข้าวเหนียวที่มีกลิ่นหอม ให้ผลผลิตสูง ทนแล้ง
ต้านทานโรคไหม้และโรคใบจุดสีน้าตาลได้ดี กข 15 เป็นพันธุ์ข้าวเจ้าที่ให้ผลผลิต เท่ากับข้าวดอกมะลิ 105 แต่
กข 15 มีอายุสั้นกว่า 10 วัน เก็บเกี่ยวได้เร็วกว่า ต้านทานโรคได้ดีกว่าข้าวดอกมะลิ 105)
11. 15. Cloning : หมายถึง กระบวนการสร้างสิ่งที่มีลักษณะทางพันธุกรรม เหมือนกันกับสิ่ง
ที่มีอยู่ก่อน มนุษย์รู้จักโคลนนิ่งมาแต่สมัยโบราณแล้ว แต่เป็นการรู้จักโคลนนิ่ง ที่
เกิดกับพืช นั่นคือ การขยายพันธุ์พืชโดย ไม่อาศัยเพศ เช่น การแตกหน่อ
18. พันธุวิศวกรรม (Genetic Engineering)
พันธุวิศวกรรม (genetic engineering) หมายถึง เทคโนโลยีที่ทาการเคลื่อนย้าย
ยีน (gene) จากสิ่งมีชีวิตสปีชีส์หนึ่งไปสู่สิ่งมีชีวิตอีกสปีชีส์หนึ่ง เป็นการสร้าง
DNA สายผสม (recombinant DNA)
สร้างสิ่งมีชีวิตรูปแบบใหม่ (novel) ที่มีคุณลักษณะแบบใหม่ ซึ่งไม่เคยปรากฏใน
ธรรมชาติมาก่อน
เปลี่ยนแปลงหน่วยพันธุกรรม
หรือ DNA ของสิ่งมีชีวิต
เคลื่อนย้ายยีนที่อยู่เหนือกฎเกณฑ์
ธรรมชาติ สิ่งมีชีวิตที่เกิดขึ้นอาจมียีน
ลูกผสมแบบใหม่
19. พันธุวิศวกรรม (genetic engineering)
คือเทคโนโลยีเกี่ยวกับ DNA เป็นการสร้าง DNA สายผสม (recombinant DNA) เพื่อให้ได้
สิ่งมีชีวิตที่มีลักษณะตามความต้องการ โดยใช้เอนไซม์ตัดจาเพาะ (restriction enzyme) และ
เอนไซม์ DNA ligase
เทคนิคการสร้าง DNA สายผสม (recombinant DNA)
1. ใช้เอนไซม์ตัดจาเพาะตัดสาย DNA ณ ตาแหน่ง ที่จาเพาะกับชนิดของเอนไซม์ DNA จะมีการ
เรียงตัวของเบสจากทิศ 5/ ไปสู่ 3/ เหมือนกันทั้งสองสาย อาจเกิดปลายเหนียว (sticky end)
คือมีนิวคลีโอไทด์สายเดี่ยวยื่นออกมา หรือ ปลายทู่ (blunt end) คือ ไม่เกิดนิวคลีโอไทด์
สายเดี่ยวขึ้นอยู่กับชนิดของเอนไซม์
2. DNA ligase ใช้ในการเชื่อมต่อสาย DNA ต่างชนิดเข้าด้วยกัน
genetically
modified
organism:
GMOs
20. 21. กระบวนการในพันธุวิศวกรรม
ประกอบด้วยกระบวนการโดยรวมคือ
1. การเตรียมยีน (gene) หรือ DNA ที่สนใจ
2. การตัด DNA อย่างจาเพาะด้วยเอนไซม์ตัดจาเพาะ
3. การเชื่อมต่อชิ้นส่วนของ DNA ที่แยกได้กับ DNA พาหะ (vector) เช่น พลาสมิด
(plasmid), phage, cosmid
4. การนาพาหะ (vector) ที่มียีนที่สนใจแทรกอยู่ หรือ DNA สายผสม ใส่เข้าไปในเซลล์ผู้รับ
(host) หลังจากนั้นเลี้ยงเซลล์ผู้รับให้แบ่งเซลล์หลายๆครั้ง ทาให้เพิ่มจานวนเซลล์ หรือ
เพิ่มปริมาณยีนที่น่าสนใจ กระบวนการนี้เรียกว่า การโคลนยีน (gene cloning)
5. การคัดเลือกเซลล์ที่มี DNA สายผสมตามที่ต้องการ
22. 26. 1. การเตรียมยีน (gene) หรือ DNA ที่น่าสนใจ
การเตรียมชิ้นส่วนยีนหรือ DNA ที่น่าสนใจมีหลายวิธีดังนี้
1. การสกัดจากเซลล์หรือเนื้อเยื่อของสิ่งมีชีวิตที่ต้องการศึกษา ซึ่งเป็น DNA ทั้งหมดในจีโนมของ
สิ่งมีชีวิตชนิดนั้น เรียกว่า genomic DNA
2. การเตรียม DNA จาก mRNA โดยใช้เอนไซม์ reverse transcriptase จะได้ DNA ที่สังเคราะห์
ขึ้นหรือถอดรหัสจาก mRNA เรียกว่า complementary DNA (cDNA)
3. การสังเคราะห์ DNA โดยวิธีทางเคมีสามารถสังเคราะห์ oligonucleotide ให้มีลาดับเบสที่
ต้องการโดยเครื่องสังเคราะห์อัตโนมัติ มี 2 วิธีที่ใช้กันอย่างกว้างขวางคือ วิธี phosphate triester
และวิธี phosphite triester
27. 30. 2. การตัด DNA อย่างจาเพาะด้วยเอนไซม์ตัดจาเพาะ
เอนไซม์ตัดจาเพาะ (Restriction enzyme or restriction endonuclease)
แบบที่ 2 (type II) เป็นเอนไซม์ที่ใช้กันมากในการ
ตัดต่อยีน
ประกอบด้วยโพลีเพพไทด์เพียงชนิดเดียว
การตัด DNA จะเกิดที่ตาแหน่งจาเพาะในบริเวณจดจา (recognition site) หรือจุดใกล้
กับบริเวณจดจา ทาให้ได้ชิ้นขนาด DNA ที่มีขนาดแน่นอน
31. 32. 35. 3. การเชื่อมต่อชิ้นส่วนของ DNA ที่แยกได้กับ DNA พาหะ (vector)
การเชื่อมต่ออาศัยเอนไซม์ ligase
การทาพันธุวิศวกรรมต้องนา DNA ที่สนใจเข้าสู่ภายในเซลล์ผู้รับ โดยอาศัย DNA พาหะ
(vector)
คุณสมบัติของ DNA พาหะ (vector)มีดังนี้
◦ มีส่วนของ DNA ที่เป็นจุดเริ่มในการจาลองตัว (origin of replication,ORI) ทาให้สามารถ
เพิ่มจานวนตัวเองได้พร้อมๆ กับ DNA ที่ใส่เข้าไป
◦ มียีนเครื่องหมาย (marker gene) สาหรับใช้ในการคัดเลือก เช่น ยีนที่ดื้อยาปฏิชีวนะ ยีนที่
เกี่ยวกับการสร้างหรือสลายกรดอะมิโนและน้าตาลบางชนิด
◦ มีบริเวณจดจาของเอนไซม์ชนิดใดชนิดหนึ่งหรือหลายชนิดเพียง ตาแหน่งเดียวในโมเลกุลของ
DNA พาหะ (unique or polylinker site)
37. ชนิดของ DNA พาหะ (vector)
ขึ้นอยู่กับขนาดของ DNA ที่นามาเชื่อมและเซลล์ผู้รับ
ตารางแสดง DNA พาหะ (vector) ชนิดต่างๆและขนาดของชิ้น DNA ที่แทรกในพาหะได้
DNA พาหะ (vector) รูปร่าง
เซลล์ผู้รับ
(host)
ขนาดของชิ้น DNA ที่แทรกได้
Plasmid DNA สายคู่, วงกลม E. coli ยาวได้ถึง 10 กิโลเบส
Bacteriophage DNA สายตรง, ไวรัส
E. coli
ยาวได้ถึง 20 กิโลเบส
Cosmid DNA สายคู่, วงกลม
E. coli
30-50 กิโลเบส
Yeast Artificial
Chromosome-YACs
โครโมโซมเทียม
,ยีสต์
yeast
250-1000 กิโลเบส (1 เมกะ
เบส)
38. 39. 41. Fig. 14-9: Cloning by cosmids. The cosmid is cut at a BglII site next to the cos site. Donor genomic DNA is cut
using Sau3A, which gives sticky ends compatible with BglII. A tandem array of donor and vector DNA results from
mixing. Phage is packaged in vitro by cutting at the cos site. The cosmid with inserts recircularizes once in the
bacterial cell.
43. 4. การนาพาหะ (vector) ที่มียีนที่สนใจแทรกอยู่ หรือ DNA สายผสมใส่เข้าไปในเซลล์ผู้รับ
ขั้นตอนการนา DNA สายผสม ใส่เข้าไปในเซลล์
ผู้รับมีหลายวิธี คือ
4.1 Transformation เป็นการนา DNA ในรูป
plasmid เข้าสู่เซลล์ผู้รับ เซลล์ผู้รับที่นิยม
ใช้กันมากคือ E. Coli โดยทาให้เซลล์ผู้รับ
เป็น competent cell ก่อน มี 3 วิธีคือ
1) การใช้สารเคมี เช่น dimethyl sulfoxide-
DMSO, CaCl2, MgCl2
2) Electroporation- ใช้กระแสไฟฟ้าทาให้
เกิดรูที่เยื่อหุ้มเซลล์ ทาให้ DNA หรือพ
ลาสมิดเข้าสู่เซลล์ได้
3) การใช้แสง laser ทาให้เกิดรูที่เยื่อหุ้มเซลล์
44. 4.2 Transfection
◦ เป็นการนา DNA ของ phage ที่มีขนาดเล็ก เช่น M13 เข้าสู่เซลล์ผู้รับ
◦ เมื่อแบคทีเรียได้รับ DNA ของphageจานวนมาก เซลล์จะแตกและ phageจะบุกรุก
เซลล์อื่นต่อไปทาให้เกิดจุดใส (clear plaque)
◦ จุดใส (clear plaque) คือ จานวน DNA ของphageที่เข้าสู่เซลล์แบคทีเรีย
4.3 Transduction
◦ เป็นการนา DNA ของcosmid ,lamda phage ที่มีขนาดใหญ่เข้าสู่เซลล์ผู้รับ
◦ โดยบรรจุลงในอนุภาคของ phage ก่อนแล้วจึงนาเข้าเซลล์
◦ วิธีนี้มีประสิทธิภาพสูงกว่า Transformation
45. 46. 5. การคัดเลือกเซลล์ที่มี DNA สายผสมตามที่ต้องการ
5.1 การคัดเลือกโดยอาศัยลักษณะ (phenotype)
◦ เป็นการอาศัยการแสดงออกของยีนเครื่องหมาย (marker gene) และมีการสร้างโปรตีน
ออกมา เช่น การสร้างเอนไซม์บางชนิดที่ทาให้เกิด clear zone ในอาหารเลี้ยงเชื้อที่มี
substrate (IPTG) อยู่ หรือพบลักษณะการดื้อยาในเซลล์ผู้รับที่ได้รับมาจากพลาสมิด
5.2 การคัดเลือกโดย DNA hybridization
◦ อาศัยการจับคู่กันของสาย DNA ที่เป็นตัวติดตาม (probe) กับ DNA เป้าหมายที่
ต้องการตรวจหาที่มีลาดับเบสคู่สมกัน บน membrane โดย probe จะติดฉลากด้วย
สารไอโซโทปหรือเอนไซม์
5.3 การคัดเลือกโดยวิธีทางอิมมิวโนวิทยา
◦ ทาได้เมื่อโคลนที่ต้องการแสดงออกได้ โดยผลิตโปรตีน แต่โปรตีนไม่แสดงลักษณะหรือ
phenotype ที่ชัดเจน เป็นการตรวจสอบโปรตีนที่เซลล์ผลิตขึ้นโดยใช้แอนติบอดีที่
จาเพาะกับโปรตีนที่ต้องการนั้น
47. 49. การคัดเลือกโดยอาศัยลักษณะ (phenotype)
Plasmid/phageที่มีส่วนของยีนที่สร้าง b-galactosidase จะสร้างเฉพาะ a-fragment
เมื่อ Plasmid/phage ถูกนาเข้าสู่แบคทีเรีย ภายใต้ภาวะที่ถูกกระตุ้นด้วย IPTG จะทาให้มี
การสร้าง b-galactosidase ในแต่ละ fragment ซึ่งสามารถเปลี่ยน X-gal ให้เป็นสีน้าเงินได้
แต่ถ้ามี foreign DNA มาเชื่อมจะทาให้เกิดการทางานของยีนดังกล่าวบกพร่อง
ไม่มีการสร้าง b-galactosidase ไม่สามารถเปลี่ยน X-gal ได้จึงให้โคโลนีสีขาว
52. 53. เทคนิค PCR
(การโคลนยีนในหลอดทดลองโดยเทคนิคพอลิเมอเรสเชนรีแอกชัน)
เป็นการเพิ่มยีนโดยใช้เครื่องมือ thermocycler ที่ควบคุมอุณหภูมิระหว่างการทางาน
อาศัยเอนไซม์ DNA พอลิเมอเรสที่สามารถทนอุณหภูมิสูงได้ โดยเป็นเอนไซม์ที่สกัดมาจาก
แบคทีเรียในน้าพุร้อน
ใช้ DNA แม่แบบที่มีส่วนของ DNA ที่ต้องการโคลน
ใช้ primer ซึ่งเป็น DNA สายสั้นๆไปเกาะกับ DNA ที่ต้องการเป็นจุดเริ่มต้นการสร้างสาย DNA
นิวคลีโอไทด์ 4 ชนิด
สารละลายบัฟเฟอร์
เทคนิค PCR สามารถเพิ่มจานวนโมเลกุล DNA ได้จานวนมากจากแม่แบบที่มีปริมาณน้อย ใน
ระยะเวลาที่สั้น แต่ไม่สามารถแทนการโคลนยีนโดยอาศัยแบคทีเรียได้เพราะ ไม่สามารถได้ผลการ
แสดงออกของยีน และยังมีโอกาสผิดพลาดได้ เนื่องจากเอนไซม์บางชนิดไม่สามารถตรวจสอบ
ความถูกต้องของลาดับนิวคลีโอไทด์ได้
55. ขั้นตอนการโคลนยีนด้วยเทคนิค PCR
1. นาสาย DNA แม่แบบ,DNAไพรเมอร์ ,นิวคลีโอไทด์ ทั้ง 4 และ DNA พอลิเมอเรส ใส่ใน
สารละลายบัฟเฟอร์ แล้วนาเข้าเครื่อง thermocycler
2. เพิ่มอุณหภูมิให้สูงขึ้น เช่น 90
๐
C เพื่อให้ DNA แม่แบบแยกออกจากกันเป็นสายเดี่ยว
3. ลดอุณหภูมิ เช่น 55
๐
C เพื่อให้ไพรเมอร์จับกับ DNA แม่แบบ
4. ปรับอุณหภูมิให้เหมาะสมกับการทางานของเอนไซม์ DNA พอลิเมอเรส เช่น 72
๐
C เพื่อให้
เกิดการจาลองสาย DNA
ทาข้อที่ 2 – 4 ซ้าหลายๆครั้ง เมื่อสิ้นสุด PCR รอบที่ n จะได้ DNA 2 n ชุด
57. ขั้นตอนของกระบวนการ PCR
1. การแยกสายดีเอ็นเอเกลียวคู่ออกจากกัน (Denaturation) ใช้อุณหภูมิ ประมาณ 94 องศา
เซลเซียส เมื่อเริ่มต้นดีเอ็นเอแม่แบบ จะอยู่ในลักษณะที่เป็นเกลียวคู่ เมื่อเพิ่มอุณหภูมิถึง
ประมาณ 94 องศาเซลเซียส จะทาให้พันธะไฮโดรเจนระหว่างคู่เบสของดีเอ็นเอถูกทาลายทาให้
เส้นดีเอ็นเอแยกออกจากกัน
2. การจับของไพรเมอร์กับ DNA แม่แบบ (Annealing) เมื่อแยกสายดีเอ็นเอออกจากกันแล้วจะ
ลดอุณหภูมิลงเหลือ 40 - 62 องศาเซลเซียส เพื่อให้ดีเอ็นเอสังเคราะห์ขนาดสั้นประมาณ
15 - 25 คู่เบส ที่เรียกว่า ไพร์เมอร์ (Primer) เข้ามาจับบริเวณที่มีลาดับเบสคู่สมกันในการ
สังเคราะห์ดีเอ็นเอ
3. การสังเคราะห์ DNA สายใหม่ต่อจากไพรเมอร์ (Extension) ใช้อุณหภูมิ ประมาณ 68-72
องศาเซลเซียส ในขั้นตอนนี้จะเป็นการสร้างสายดีเอ็นเอต่อจากไพร์เมอร์ โดยอุณหภูมิที่ใช้จะ
พอเหมาะกับการทางานของ Taq DNA polymerase
60. 62. การวิเคราะห์ DNA ด้วยวิธีเจลอิเล็กโทรโฟริซิส
(gel electrophoresis)
คือ การแยกโมเลกุลDNA ที่มีขนาดแตกต่างกันออกจากกันในสนามไฟฟ้า โดยให้ DNA
เคลื่อนที่ผ่านตัวกลางที่เป็นแผ่นวุ้น เช่น อากาโรสเจล โมเลกุลของDNA จะเคลื่อนที่เข้าหา
ขั้วบวก (anode) โดยโมเลกุล DNA ขนาดใหญ่เคลื่อนที่ได้ช้ากว่าโมเลกุลขนาดเล็ก และ
เปรียบเทียบการเคลื่อนที่กับโมเลกุล DNA ที่ทราบขนาด (DNA molecular weight marker) ทา
ให้ทราบขนาดโมเลกุล DNA ที่ศึกษา
DNA ในสารละลายจะใสไม่มีสีต้องย้อมด้วย อีธิเดียมโบรไมด์ จะเรืองแสงฟลูออเรสเซนซ์
ภายใต้รังสีอัลตราไวโอเลตเป็นสีชมพู
68. RFLP
(restriction fragment length polymorphism)
คือความแตกต่างหรือความหลากหลายของขนาดDNAที่เกิดจากการตัดด้วยเอนไซม์ตัดจาเพาะ
ใช้เป็นเครื่องหมายทางพันธุกรรมได้
ศึกษาจีโนมมนุษย์ E.coli ยีสต์ หนู พืชวงศ์ผักกาด ข้าว เป็นต้น
78. 83. 84. 86. ลายพิมพ์ DNA (DNA Fingerprint)
DNA ทั้งหมดของสิ่งมีชีวิตนั้นประกอบด้วย 2 ส่วน
coding DNA ทาหน้าที่ควบคุมการสร้างโปรตีนที่มีความสาคัญต่อกลไกต่างๆ ภายใน
ร่างกาย ซึ่งจะมีอยู่เพียงร้อยละ 5 ของชุด DNAทั้งหมด
noncoding DNA ร้อยละ 95 มีส่วนหนึ่งที่เป็นเบสซ้าต่อเนื่อง (tandem repeat) อยู่หลาย
ตาแหน่ง
Tandem Repeat
เบสซ้าต่อเนื่องนี้เองที่นามาทาเป็นลายพิมพ์ดีเอ็นซึ่งเป็นเครื่องหมายพันธุกรรม ทาให้สามารถรู้
ลักษณะของจานวนการซ้าของท่อน DNA แต่ละชุดในแต่ละตาแหน่งบนสาย DNA ของ
สิ่งมีชีวิตและบุคคลได้
สามารถใช้ความแตกต่างกันของขนาดและจานวนการซ้าของท่อน DNA แต่ละชุดนี้ บ่งบอกถึง
ข้อมูลพันธุกรรมเฉพาะของแต่ละบุคคลได้
88. หลักการทางานของเทคโนโลยีลายพิมพ์ DNA
1. เก็บตัวอย่างเซลล์ ตัวอย่างต้องมี DNA ที่มี
คุณภาพ ไม่เสื่อมสลาย (ปัจจัยที่ทาให้ DNA เสื่อม
สลายคือ ระยะเวลา อุณหภูมิ ความชื้น แสงแดด
สารเคมี จุลินทรีย์ ฯลฯ)
2. สกัด DNA จากเซลล์ของตัวอย่าง
3. ตรวจลายพิมพ์ดีเอ็นเอ หลักการคือ เลือกตัด
DNA ในส่วนที่แสดงเอกลักษณ์เฉพาะบุคคล โดยใช้
restriction enzyme จากนั้นนาชิ้นส่วน DNA ที่ถูก
ตัดมาวิเคราะห์ตามขนาดด้วยวิธี Gel
Electrophoresi
4. แปลผลลายพิมพ์ DNA โดยการอ่านผลจาก
ลักษณะตาแหน่งของแถบดีเอ็น หรือกราฟที่ได้
90. 92. 96. การประยุกต์ใช้เทคโนโลยีของ DNA
1. เชิงการแพทย์และเภสัชกรรม
การวินิจฉัยโรค
การบาบัดด้วยยีน
การสร้างผลิตภัณฑ์ทางเภสัชกรรม
2. เชิงนิติวิทยาศาสตร์
3. เชิงการเกษตร
การทาฟาร์มสัตว์เพื่อสุขภาพมนุษย์
การสร้างสิ่งมีชีวิตดัดแปลงพันธุกรรม (transgenic organisms)
4. การใช้พันธุศาสตร์เพื่อศึกษาค้นคว้าหายีนและหน้าที่ของยีน
5. การประยุกต์ใช้เพื่อสิ่งแวดล้อม
97. การสร้างฟาร์มสัตว์ที่เสมือนโรงงานผลิตยาด้านการแพทย์ เช่น ผลิตโปรตีนยับยั้งเอนไซม์
ทาลายเซลล์ปอดของโรคซิสติกไฟโบรซิส
แยกเซลล์ไข่ออกจากเพศเมียฉีดยีนที่ต้องการใส่ในนิวเคลียสเซลล์ไข่แล้วผสมพันธุ์ในหลอด
ทดลองถ่ายฝากเข้าตัวผู้รับ
การสร้างพืชดัดแปลงพันธุกรรม ถ่ายยีนที่ต้องการโดยใช้แบคทีเรีย หรือใช้ gun gene
ผลจากการประยุกต์ใช้ในเชิงการเกษตรด้านพืช
พืชต้านทานแมลง โดยถ่ายยีนบีทีให้กับพืช
พืชต้านทานโรค เช่น โรคใบด่างจุดวงแหวนในมะละกอ
พืชต้านทานสารปราบวัชพืช
พืชเพิ่มคุณค่าทางอาหาร เช่น ข้าวสามารถสร้างวิตามินเอ
พืชที่ยืดอายุของผลผลิตได้ยาวนานขึ้น ทาให้ไม่สร้างเอทิลีน
การใช้วิธีโมเลกูลาร์ บรีดดิง เพื่อทาเครื่องหมายในยีนสาหรับการคัดเลือกรุ่นต่อไป
สิ่งมีชีวิตดัดแปลงพันธุกรรม
(genetically modified organism: GMOs)
99. 102. 105. 107. 114. ความก้าวหน้าทางพันธุศาสตร์และเทคโนโลยีชีวภาพ
1. ด้านการเกษตร สร้างพืช GMO ลักษณะตามที่ต้องการ เช่น ต้านทานโรค ทนแล้ง ให้ผลผลิตคุณค่าทางอาหาร
2. การพัฒนาผลิตสัตว์ เช่น การผสมเทียม การถ่ายฝากตัวอ่อน การโคลน
3. การแพทย์และสาธารณสุข เช่น การตรวจโรคหาความบกพร่องก่อนแต่งงาน การรักษาโรคด้วยวิธียีนบาบัด
4. เทคโนโลยีดีเอ็นเอ เช่น การตรวจสอบดีเอ็นเอของสิ่งมีชีวิตเพื่อการพิสูจน์เอกลักษณ์บุคคล พันธุ์พืช พันธุ์สัตว์
117.